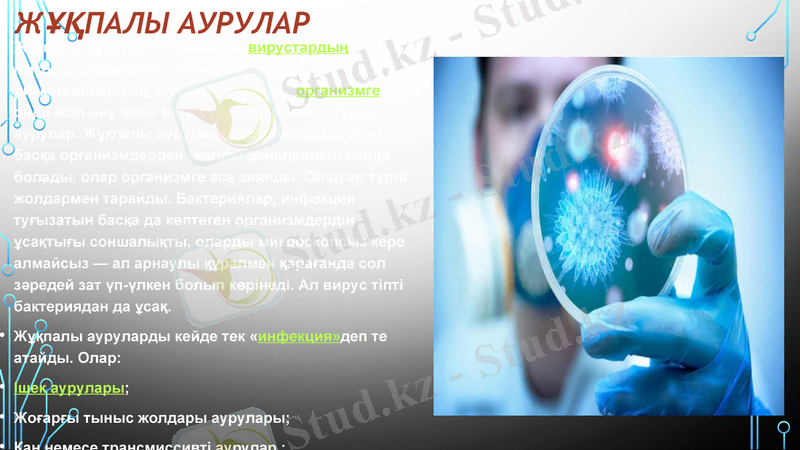
Slide 8

Ішек және жұқпалы аурулардың түрлері, эпидемиологиясы және алдын алу шаралары



Ішек пен жұқпалы аурулар
Орындаған :Созақбай Сымбат
Тексерген:Сыдырбекова Ақбала
Топ:22 «б»

Жоспар:
1. Ішек аурулары және алдын алу шаралары
2. Жұқпалы аурулар
3. Жұқпалы аурулардың түрлері және алдын алу шаралары

Ішек аурулары және алдын алу шаралары
Ішек аурулары (мысалы А-гепатиті) вирус ас қорыту жолдарына ауыздан кіріп, ішектен нәжіспен бірге шығады.
Тыныс жолдары ауруында шырышты қабықтар зақымданады және организмге вирус: ауамен кіреді.
Қан немесе трансмиссивті аурулар (әртүрлі энцефаломиелиттер, гемаррагиялық безгектер) аурудан сау адамға және жануарларға қан; сорғыш насекомдарарқылы беріледі, кейде қосалқы көмекшілері болады, көбінесе табиғи-ошақты болып келеді.
Сыртқы қабықтардың аурулары (құтыру, аусыл, делбе) жанасудан, қарым-қатынаста болудан тарайды. Вирустардьң организмде өсіп-өну және шоғырлану ерекшеліктеріне сай оларды ошақты және жалпы деп бөледі.

Біріншісінде қоздырғыштардың әсері тек енген жерде көрінеді, ол сол жерде есіп-өнеді (мысалы ішекте, не тыныс жолдарында) . Екіншісінде вирустар енген жерінде көбейіп, денеге тарайды да, басқа ағзаларда екінші үлкен ошақ құрайды (шешек, қызылша, полиомиелит) . Аурудың мерзімінің ұзақтығына, белгілерінің көрінуіне және қоздырғыштың сыртқы ортаға шығып тұруына байланысты олар жіті және созылмалы болып бөлінеді. Жітілері тез жазылады, вирустан да тез құтылады. Ал созылмалысы біресе айығып, біресе қайталап көпке созылады. Өз алдына бір бөлек түрі - баяу ауру. Бұл түрінде вирус организмде көпке дейін сақталып, ауру ұзаққа созылады және клиникалық белгілері көмескілеу болады. Ал ауру белгілерінің мүлдем болмайтын түрін инаппаранттык деп атайды. Мұнда организмнен ауру қоздырғышы, шығып кетеді де, иммунитет пайда болады. Аурудың латентті (жасырын) деген де түрі бар. Онда вирус организмде өте ұзақ уақыт өмір сүреді.

ЖҰҚПАЛЫ АУРУЛАР
Жұқпалы аурулар - зардапты вирустардың, микоплазмалардың, хламидийлердің, риккетсиялардың, спирохеталардың организмге еніп, онда өсіп-өну және өмір сүру салдарынан туатын аурулар. Жұқпалы аурулар бактериялардан және басқа организмдерден (жанды денелерден) пайда болады, олар организмге аса зиянды. Олар әр түрлі жолдармен тарайды. Бактериялар, инфекция туғызатын басқа да көптеген организмдердің ұсақтығы соншалықты, оларды микроскопсыз кере алмайсыз - ал арнаулы құралмен қарағанда сол зәредей зат үп-үлкен болып көрінеді. Ал вирус тіпті бактериядан да ұсақ.
Жұқпалы ауруларды кейде тек «инфекция»деп те атайды. Олар:
Ішек аурулары;
Жоғарғы тыныс жолдары аурулары;
Қан немесе трансмиссивті аурулар ;
Сыртқы қабықтардың аурулары болып бөлінеді.

Жұқпалы аурулар пайда болуының үш факторы бар:
ауру қоздырғышы (микроб),
сыртқы орта және
қабылдаушы сезімтал организм.
Ауру қоздырғышына әр түрлі патогенді микроорганизмдер (мыс., бактерия, вирус, саңырауқұлақ, қарапайымдылар, риккетсия, микоплазма, хламидия, т. б. ) жатады. Бұлар адам организміне әр түрлі жағдайда енеді. Мысалы, іш сүзегі, паратиф, дизентерия, т. б. - су, тағам, шыбындар арқылы; тұмау, қызылша, дифтерия, т. б. - ауру адамнан; әр түрлі тері дерттері - ауру адам мен жануарлардан; бөртпе сүзек, кене энцефалиті, безгек - сау адамға ауру адамнан (жануарлардан) қан сорғыш буынаяқтылар (мысалы, бит, безгек масасы, кене, т. б. ) арқылы; сондай-ақ құрсақтағы анасының қанымен жұғады.
Жұқпалы аурулар
жасырын (инкубациялық),
күмәнді (продромалдық),
ауру дамуы және
айығу (реконвалесцениттік) кезеңдерінен тұрады.

Әрбір кезеңнің өту мерзімі аурудың түріне, организмнің жағдайына байланысты болады. Жалпы Жұқпалы ауруларға шалдыққан адамдарға ортақ белгі: селсоқтанып мазасы кетеді, дене қызуы көтеріледі, басы ауырады, ұйқысы қашады. Бауыр мен талақтың ісінуі мүмкін. Осындай ерекше белгілеріне қарай іш сүзегін тырысқақтан, безгекті бөрте сүзектен, т. с. с. ажыратуға болады.
20 ғасырда диагноз қою, емдеу және одан сақтану әдістерінің жетілдіруіне байланысты Жұқпалы аурулардың кейбір түрлері жойылды. Бірақ микроорганизмдердің эвол. даму өзгергіштігінің, әлеуметтік, экология, ғұрып-дәстүрлік, т. б. себептердің нәтижесінде Жұқпалы аурулардың жаңа түрлері пайда болды. Мысалы, жүре пайда болатын иммундық тапшылық синдромы, гепатиттің ерекше түрлері, т. б.
Жұқпалы аурулардың белгісі білінісімен-ақ санитарлық-эпидемиология стансаларға хабарлануы тиіс. Науқас адам ауруханаға алынып, аурудың түріне қарай емделеді. Жұқпалы аурулар клиникалық медицинаның арнайы бір зерттейтін саласы болғандықтан - бактериология, вирусология, иммунология, эпидемиология, паразитологиямен тығыз байланысты.

Жұқпалы аурулардың түрлері
Жұқпалы аурулар инфекциялық аурулар (лат. іnfectіo-жұқтыру) :
тірі организмдерге ауру тудырушы микроорганизмдердің (бактерия, риккетсия, вирус, саңырауқұлақ) енуінен пайда болатын кесел;
осы аурулардың белгісі мен даму барысын зерттеп, оның дәл диагнозын қойып, емдейтін клиникалық медицинаның арнайы бір саласы.
- Іс жүргізу
- Автоматтандыру, Техника
- Алғашқы әскери дайындық
- Астрономия
- Ауыл шаруашылығы
- Банк ісі
- Бизнесті бағалау
- Биология
- Бухгалтерлік іс
- Валеология
- Ветеринария
- География
- Геология, Геофизика, Геодезия
- Дін
- Ет, сүт, шарап өнімдері
- Жалпы тарих
- Жер кадастрі, Жылжымайтын мүлік
- Журналистика
- Информатика
- Кеден ісі
- Маркетинг
- Математика, Геометрия
- Медицина
- Мемлекеттік басқару
- Менеджмент
- Мұнай, Газ
- Мұрағат ісі
- Мәдениеттану
- ОБЖ (Основы безопасности жизнедеятельности)
- Педагогика
- Полиграфия
- Психология
- Салық
- Саясаттану
- Сақтандыру
- Сертификаттау, стандарттау
- Социология, Демография
- Спорт
- Статистика
- Тілтану, Филология
- Тарихи тұлғалар
- Тау-кен ісі
- Транспорт
- Туризм
- Физика
- Философия
- Халықаралық қатынастар
- Химия
- Экология, Қоршаған ортаны қорғау
- Экономика
- Экономикалық география
- Электротехника
- Қазақстан тарихы
- Қаржы
- Құрылыс
- Құқық, Криминалистика
- Әдебиет
- Өнер, музыка
- Өнеркәсіп, Өндіріс
Қазақ тілінде жазылған рефераттар, курстық жұмыстар, дипломдық жұмыстар бойынша біздің қор #1 болып табылады.



Ақпарат
Қосымша
Email: info@stud.kz